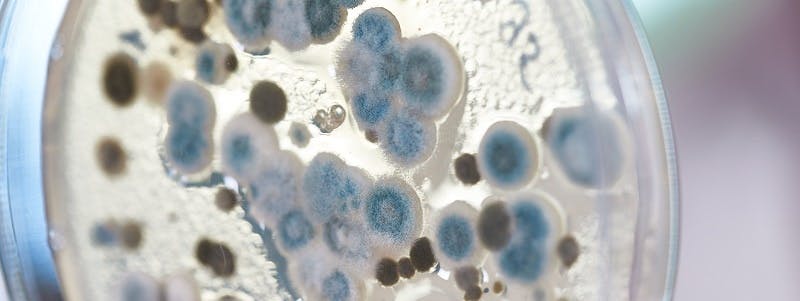

Das Master-Studium
Der Masterstudiengang Lebensmittelsicherheit wird an der Hochschule Fresenius in Idstein in Kooperation mit der Hochschule Geisenheim angeboten. Gemeinsam mit der Hochschule Geisenheim werden Ihnen an den beiden Standorten die Kompetenzen vermittelt, die Sie für Ihre zukünftige berufliche Tätigkeit in der Lebensmittelwirtschaft benötigen. 
Berufsbild und Karrierechancen
Mit einem Masterabschluss in Lebensmittelsicherheit (M.Sc.) haben Sie verschiedene Möglichkeiten, beruflich Fuß zu fassen. Mit diesem Master of Science können Sie beispielsweise in folgenden Branchen arbeiten:
- Qualitätssicherung und -management in der Lebensmittelwirtschaft
- Überwachung, Management und Optimierung von Produktionsprozessen
- Entwicklung von Produkten und von neuen Herstellungsverfahren
- Einkauf und Beurteilung von Rohstoffen
- Betriebskontrolle, Produktionsleitung oder technische Direktion in Betrieben der Lebensmittelindustrie
- Forschung und Entwicklung in Unternehmen der Lebensmittelwirtschaft
- Auditieren von Lebensmittelbetrieben und deren Zulieferanten

Studienplan und Studienschwerpunkte
Dieser Masterstudiengang ist interdisziplinär ausgerichtet und gewährt Ihnen Einblicke in die Analytik und Technologie sowie in Qualität und Recht. Sie lernen, fachlichen Fragestellungen ganzheitlich nachzugehen und somit einen wichtigen Beitrag zur Sicherheit von Lebensmitteln, Futtermitteln und Bedarfsgegenständen zu leisten. Folgende Inhalte erwarten Sie z. B. in den vier Semestern innerhalb der Pflichtmodule des Masterstudiengangs Lebensmittelsicherheit:
- Angewandte Bioanalytik
- Angewandtes Qualitätsmanagement
- Lebensmitteltoxikologie
- Lebensmittel- und Produkthaftungsrecht
- Sensorische Analyse
- Technologie neuartiger Lebensmittel
Mit den Wahlpflichtmodulen spezialisieren Sie sich in Bereichen, die Sie besonders interessieren. Aus dem umfassenden Modulkatalog können Sie unter anderem wählen:
- Krisenkommunikation
- Persönlichkeitsentwicklung und Zeitmanagement
- Prozessoptimierung
- Wertstoffgewinnung aus Früchten und Gemüse
Eine weitere Besonderheit an dem Studiengang der Lebensmittelsicherheit (M.Sc.) in Geisenheim und Idstein ist die Beschäftigung mit der Technologie alkaloidhaltiger Getränke (Kaffee, Tee und Kakao). Dies wird in dieser Form an keiner anderen Hochschule in Deutschland angeboten.
Zulassungsvoraussetzungen
Um den Masterstudiengang Lebensmittelsicherheit (M.Sc.) studieren zu können, benötigen Sie einen Bachelorabschluss mit mindestens 180 Credits im Bereich Lebensmittelsicherheit, Lebensmittelchemie, Lebensmitteltechnologie oder einem fachlich vergleichbaren Studiengang. Dieser kann beispielsweise die Ernährungswissenschaften oder die Getränketechnologie sein. Je nach Bachelorabschluss ist eine Einzelfallentscheidung über eine Aufnahmeprüfung erforderlich. Die Bewerbung für den Masterstudiengang Lebensmittelsicherheit (M.Sc.) erfolgt über die Hochschule Geisenheim University. Weitere Informationen zum Bewerbungsprozess erhalten Sie bei unserer Partnerhochschule:
Bewerbungsfristen
Die Bewerbungsfristen entnehmen Sie unserer Website.
Gebühren
Die Hochschule Fresenius ist eine Hochschule in freier Trägerschaft, deren Studiengänge staatlich anerkannt, aber nicht staatlich refinanziert werden. Aus diesem Grund müssen wir für das Studium Gebühren erheben.* Für eine detaillierte Kostenübersicht besuchen Sie bitte die Website.
*ggf. wird eine einmalige Anmeldegebühr fällig.


